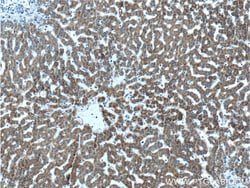
GCDH Rabbit anti-Human, Mouse, Rat, Polyclonal, Proteintech 20 &mu;L; Unconjugated:Antibodies,

missing translation for 'onlineSavingsMsg'
Learn More
Learn More
GCDH Rabbit anti-Human, Mouse, Rat, Polyclonal, Proteintech
Rabbit Polyclonal Antibody
Brand: Proteintech 14930-1-AP-20UL
This item is not returnable.
View return policy
Description
The protein encoded by this gene belongs to the acyl-CoA dehydrogenase family. It catalyzes the oxidative decarboxylation of glutaryl-CoA to crotonyl-CoA and CO(2) in the degradative pathway of L-lysine, L-hydroxylysine, and L-tryptophan metabolism. It uses electron transfer flavoprotein as its electron acceptor. The enzyme exists in the mitochondrial matrix as a homotetramer of 45-kD subunits. Alternatively spliced transcript variants encoding different isoforms have been identified.Specifications
| GCDH | |
| Polyclonal | |
| Unconjugated | |
| GCDH | |
| ACAD5, GCD, GCDH | |
| Rabbit | |
| Antigen Affinity Chromatography | |
| RUO | |
| 2639, 270076, 364975 | |
| -20°C | |
| Liquid |
| Immunohistochemistry (Paraffin), Western Blot | |
| 0.14 mg/mL | |
| PBS with 50% glycerol and 0.02% sodium azide; pH 7.3 | |
| Q60759, Q92947 | |
| Gcdh | |
| GCDH Fusion Protein Ag6713 | |
| 20 μL | |
| Primary | |
| Human, Mouse, Rat | |
| Antibody | |
| IgG |
Product Content Correction
Your input is important to us. Please complete this form to provide feedback related to the content on this product.
Product Title
Spot an opportunity for improvement?Share a Content Correction